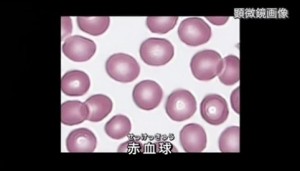
2015y08m29d_140442519

血液の機能・仕組みを知ろう! 人体の不思議シリーズ 血液

人体の不思議 血液 3:16
血液。 血液は、ヒトの体重の13分の1を占め、その主なはたらきは、全身の細胞に栄養分や酸素を運搬したり、二酸化炭素や老廃物を運び出すことです。
血液は、ヒトの体重の13分の1を占め、その主なはたらきは、全身の細胞に栄養分や酸素を運搬したり、二酸化炭素や老廃物を運び出すことです。
血液が体内を流れる速さは、安静時でも、一分間に全身をひと回りする速さで、運動を行っているときは、その数倍の速さになります。
また、生体に侵入する、細菌や異物などを、破壊したり無毒化したりする、生体防御作用や、体温を下げる役割ももっており、臓器のひとつといえます。
血液全体は赤い液体ですが、成分は細胞成分と液状成分とで構成されています。
採血した血液を遠心機にかけたり、しばらく垂直に立てておくと、上は薄い黄色をした透明の層となり、下は、赤い層になります。
この2つの層の境界に、白っぽい模様に見える部分は、白血球層です。透明部分が液状成分で血漿といい、そのほかは、細胞成分で、大部分は赤血球ですが、わずかに、白血球、血小板があります。
赤血球には、核がなく、鉄を含有するヘモグロビンを多量に含んでいます。血液が赤く見えるのは、この、ヘモグロビンが、赤い色をしているためで、ヘモグロビンは、肺での、ガス交換に、重要な役割を果たしています。
赤血球の寿命は、およそ120日で、1立方ミリメートルの中には、およそ450から500万個があります。また、1立方ミリメートルの中には、白血球が、6000から8000個、血小板は、30万個前後あります。
白血球は核をもっていて、リンパ球、好中球、好酸球、好塩基球、単球の、5種類に分けられます。
5種類の白血球は、それぞれ役割をもっていますが、感染症やアレルギー反応、微生物の処理など、体を病気から守るはたらきをしています。
血小板は、血液を凝固する、止血というはたらきをもちます。血小板が少なくなると、出血しやすくなったり、出血が止まりにくくなったりします。
全ての血液細胞は、骨髄で作られています。骨髄には、血液細胞のもととなる細胞、造血幹細胞があり、最初は、一種類しかないこの細胞が、しだいに分化して、最終的には、赤血球や白血球となっていきます。
~~~
補足修正
血液は、骨髄で作られているとされていますが、本当は、小腸で作られています。騙されてはいけません^^
このブログの著者はこちら!フォロー大歓迎です^^♫
↓ ↓ ↓

★私のプロフィール:松本 康男(やすボーイ)大阪在住のフリープログラマー。ちょっとしたことから体調を壊してしまい・・ずっと治らない日々が続く。そんな中、奇跡的に日本一の中医学の先生に出会う。その情報を元に「東洋医学健康アドバイザー」としてFBで情報発信すると、またたく間に大人気に!!お友達5000人・フォロワー数11,430人・さらには、Facebook日本人気ユーザーランキング280位に至る!TV・マスコミ・新聞などの歪んだ噓の情報ではなく、真実の情報をあなたにお伝えしています。
本当の情報を知りたい人だけ、こちらから私のFacebookをフォローして下さい
⇒ Facebookフォローはこちら!
Instagramのフォローはこちらできます。
⇒ Instagramフォローはこちら!
★facebookやtwitterでのシェアやRTも大歓迎です^^♫


このブログや記事に共感してくれたあなたへ^^
私の無料健康メルマガへのお誘いです^^下からどうぞ ↓ ↓
 ↑ ↑ コチラからどうぞ!! ↑ ↑
私の健康Facebookグループのメンバーは、現在6,430人 そして、健康メールマガジンは、現在4,160人の読者がいます。
いちばん重要な情報は、メルマガで流しています!大切な情報を逃したくない方は、登録をお勧めします!
↑ ↑ コチラからどうぞ!! ↑ ↑
私の健康Facebookグループのメンバーは、現在6,430人 そして、健康メールマガジンは、現在4,160人の読者がいます。
いちばん重要な情報は、メルマガで流しています!大切な情報を逃したくない方は、登録をお勧めします!










この記事へのコメントはありません。